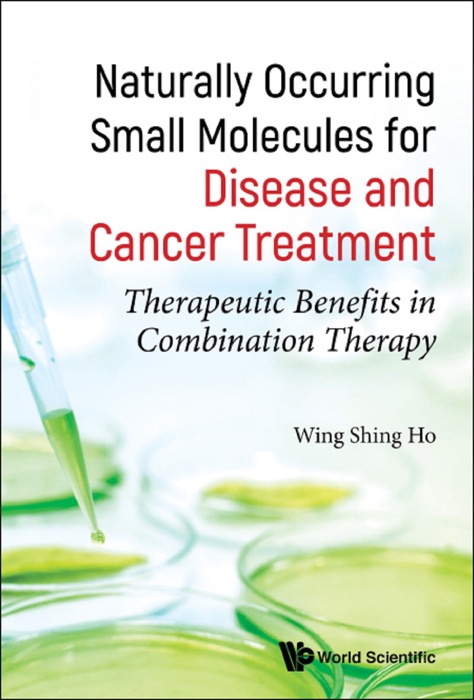
Naturally Occurring Small Molecules for Disease and Cancer Treatment

[Download] "Naturally Occurring Small Molecules for Disease and Cancer Treatment" by Wing Shing Ho * eBook PDF Kindle ePub Free
eBook details
- Title: Naturally Occurring Small Molecules for Disease and Cancer Treatment
- Author : Wing Shing Ho
- Release Date : January 18, 2019
- Genre: Medical,Books,Professional & Technical,Health, Mind & Body,
- Pages : * pages
- Size : 9223 KB
Description
Western drugs and target medicines for disease treatment come with undesirable side effects that have limited their use in patients for an extended period of time. It is warranted to develop a treatment strategy with alternative medicines to reduce toxicity relating to drugs, in particular, cancer drugs. Thus, a combination therapy with herbal medicines provides a more effective treatment method for hard-to-treat diseases. The recent breakthroughs in naturally occurring small molecules from herbal medicines have provided experimental evidence and are clinically significant in treatment strategies.
This unique volume presents the recent developments in the field of herbal medicines for the treatment of diseases and cancer. Recent progress on small molecules isolated from herbal medicines that exhibit therapeutic benefits in humans is highlighted. The book provides an overview of the significant discoveries and pioneering contributions of herbal medicines in combination with other drugs; the author's evaluation of the combination therapy in cancer treatment; and a recent discovery of crocodile tissue extract with pharmacological properties.
Contents:Principles of Pharmacology of Cancer Drug TreatmentPlant MoleculesHerbal MedicinesTherapeutic Uses of Small MoleculesMechanism of ActionIntegration and Control of the Human Body During TreatmentCytotoxic Plant Molecules and ImmunopharmacologyPotential Beneficial Effects of Plant ProductsAdverse Drug ReactionsTreatment of Cancer with Natural ProductsPharmaceutical Development of Potential Cancer Drugs
Readership: Medical students, researchers in medicinal chemistry, pharmacologists and both undergraduate and postgraduate students in pharmacology and those working in herbal and alternative medicine.Therapeutic Benefits;Integrated Medicine;Anti-Cancer;Anti-Inflammatory;Small Molecules;Cancer Treatment;New Drugs;Combination Therapy;Natural Plant Products;Crocodile Tissue Extract0Key Features:The book is unique in providing useful information for treatment of cancers and other diseasesIt is the first time that crocodile tissue extract has been shown to produce health benefits in humansSmall naturally occurring molecules from herbal medicines provide insight into new drug development
Post a Comment for "[Download] "Naturally Occurring Small Molecules for Disease and Cancer Treatment" by Wing Shing Ho * eBook PDF Kindle ePub Free"